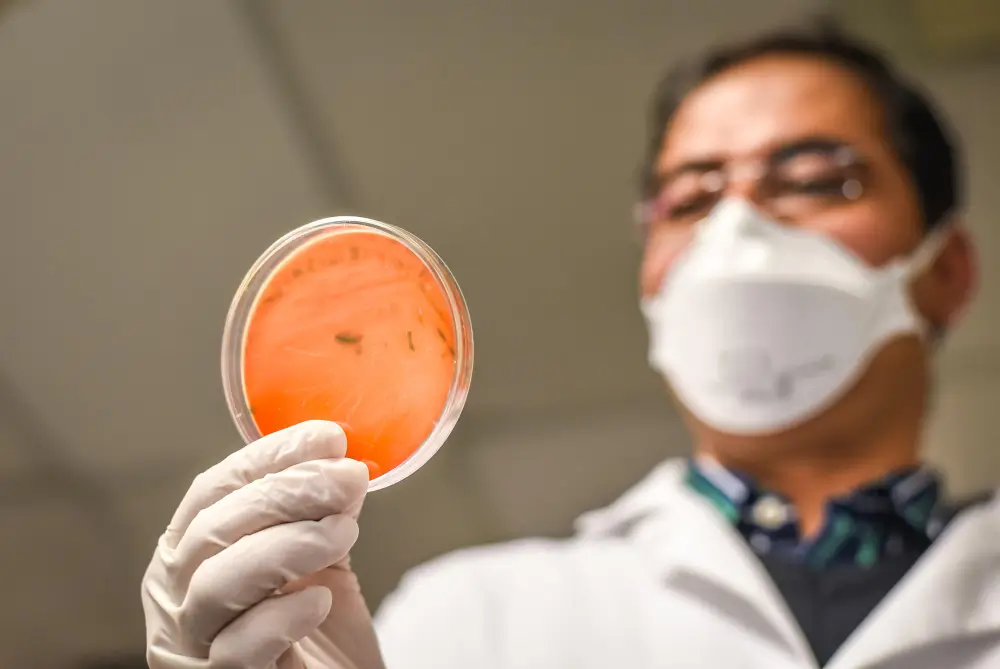

When Indian intended parents in the USA are looking at egg donation, one of the key choices to make is fresh donor eggs versus frozen donor eggs. Both have their advantages, disadvantages, and costs. Making the best choice can make a difference in your timing, success, and expenses. This blog weighs them side by side, helping you make the best decision for your family.
What Do Indian Egg Donors Say About Costs?
Indian Egg Donors say that U.S. donor fees (donor + IVF package) usually range from $6000–$15,000 for donor compensation and screening, while the IVF, medication, lab, and related medical fees contribute another $15,000, making the entire egg donor cycle cost approximately $25,000.
We will use these figures when comparing fresh vs. frozen eggs in this blog.
Fresh Donor Eggs
How It Works
- The donofertilisedpient goes through coordinated stimulation cycles simultaneously.
- Eggs are retrieved fresh and immediately fertilized and transferred (or frozen later).
- Requires more scheduling and synchronization.
Advantages
- Typically, more embryos are created, giving more flexibility.
- Slightly higher success rates in many cases.
- You can choose from a wider range of donor profiles, including immediate ones.
Challenges
- Needs careful timing and coordination.
- More intricate logistics.
- Mildly greater procedural complexity.
Cost Context
As fresh cycles require more coordination, certain clinics or agencies might charge an additional premium. Nevertheless, as the Indian Egg Donors‘ pricing model is based on packages, your overall cost might still fit in most situations.
Frozen Donor Eggs
How It Works
- Eggs are picked up earlier by the donor, frozen (vitrified), and kept in storage.
- You buy a set of frozen eggs and arrange a transfer on your schedule.
- No requirement to synchronize menstrual cycles with the donor.
Advantages
- Improved scheduling convenience.
- Frequently quicker to begin, as you don’t have to wait for synchronization of the donor.
- Less likelihood of cycle cancellation due to a timing mismatch.
Challenges
- Marginally lower egg survival rate (though newer technology blurs this disparity).
- Fewer embryos in some instances.
- The pool of selection can be less broad at times.
Cost Context
Since there is less synchronization required, there are frozen options available that are somewhat less expensive or have reduced margins. However, utilizing a full-service agency like Indian Egg Donors, your total will still approximate, particularly after considering IVF and medications, and storage fees.
Side-by-Side Comparison
| Feature | Fresh Donor Egg Cycle | Frozen Donor Egg Cycle |
|---|---|---|
| Timing | Requires cycle coordination between donor & recipient | More flexible, schedule on your terms |
| Embryo yield | Typically provides more embryos | Can produce fewer embryos |
| Success rate | Slightly greater in most clinics | Slightly reduced survival, but recovering |
| Risk of cancellation | Greater if timing mismatches | Lower risk through adaptability |
| Cost difference | Slight premium in some instances | Slight discount in some environments |
| Convenience | More logistical requirements | More convenience in scheduling |
Which Option Suits Indian Intended Parents Best?
Considerations
- Timeline priority : If you want to start early or not wait for a donor’s cycle, frozen eggs provide flexibility.
- Availability of Indian donor profiles : Fresh cycles tend to permit choosing from a larger, active donor population; frozen batches may only provide limited Indian donor supplies.
- Budget tolerance : While prices will tend to be equal in total, frozen may decrease the probability of additional expense due to the cancellation of the cycle.
- Emotional peace of mind : Intended parents feel more secure with fresh cycles because they perceive a greater yield and outcome.
Tips to Make the Best Choice
- Request your agency’s success rate for fresh vs. frozen cycles.
- Assess how many embryos you would potentially need, depending on age and fertility history.
- Look into the future use or storage of leftover embryos.
- Examine the donor pool match for Indian ethnicity in both fresh and frozen programs.
Why Rely on Indian Egg Donors for This Decision
We at Indian Egg Donors assist Indian-origin families through these decisions. We offer you detailed donor profiles, explicit success data, and open cost disclosure. We assist both fresh and frozen programs and provide you with the best choice based on your requirements.
You may contact us at (212) 661-7177 to consult on what suits you best.
Conclusion
Both fresh and frozen Indian donor eggs provide avenues to parenthood. The ideal option is a matter of your timeline, desired flexibility, and emotional preference. With the Indian Egg Donors’ cost baseline, either will prove suitable if informed by seasoned agency guidance. Consider your priorities thoughtfully, discuss freely with your team, and select what most resonates with your vision for family.
Frequently Asked Questions (FAQs)
Q1. Is the success rate much lower with frozen eggs?
Ans : New freezing (vitrification) has really improved results. Most labs have similar success now with high-quality frozen eggs if properly handled.
Q2. Can I convert a fresh cycle into a frozen one?
Ans : Yes. If you get more eggs than required, the surplus can be frozen and used in the future.
Q3. Do fresh cycles cost significantly more at Indian Egg Donors?
Ans : In general, no, they package both options, although there are minor premium adjustments that can be made.
Q4. What if no Indian donor frozen eggs are available?
Ans : If the frozen inventory of Indian donors is not readily available, you might have to wait or loosen your matching criteria—or choose fresh cycle matching.

Dr. Pooja Patel
Dr. Pooja Patel is a Chief Surrogacy Coordinator at Surrogacy4all. She has 10 years of experience in Anesthesiology and critical care medicine.
She received her medical degree from Seth GS Medical College and K.E.M Hospital in India. She then completed an internship. She finished her Anesthesia residency at Grant Govt Medical College and JJ Group of Hospitals in India.




